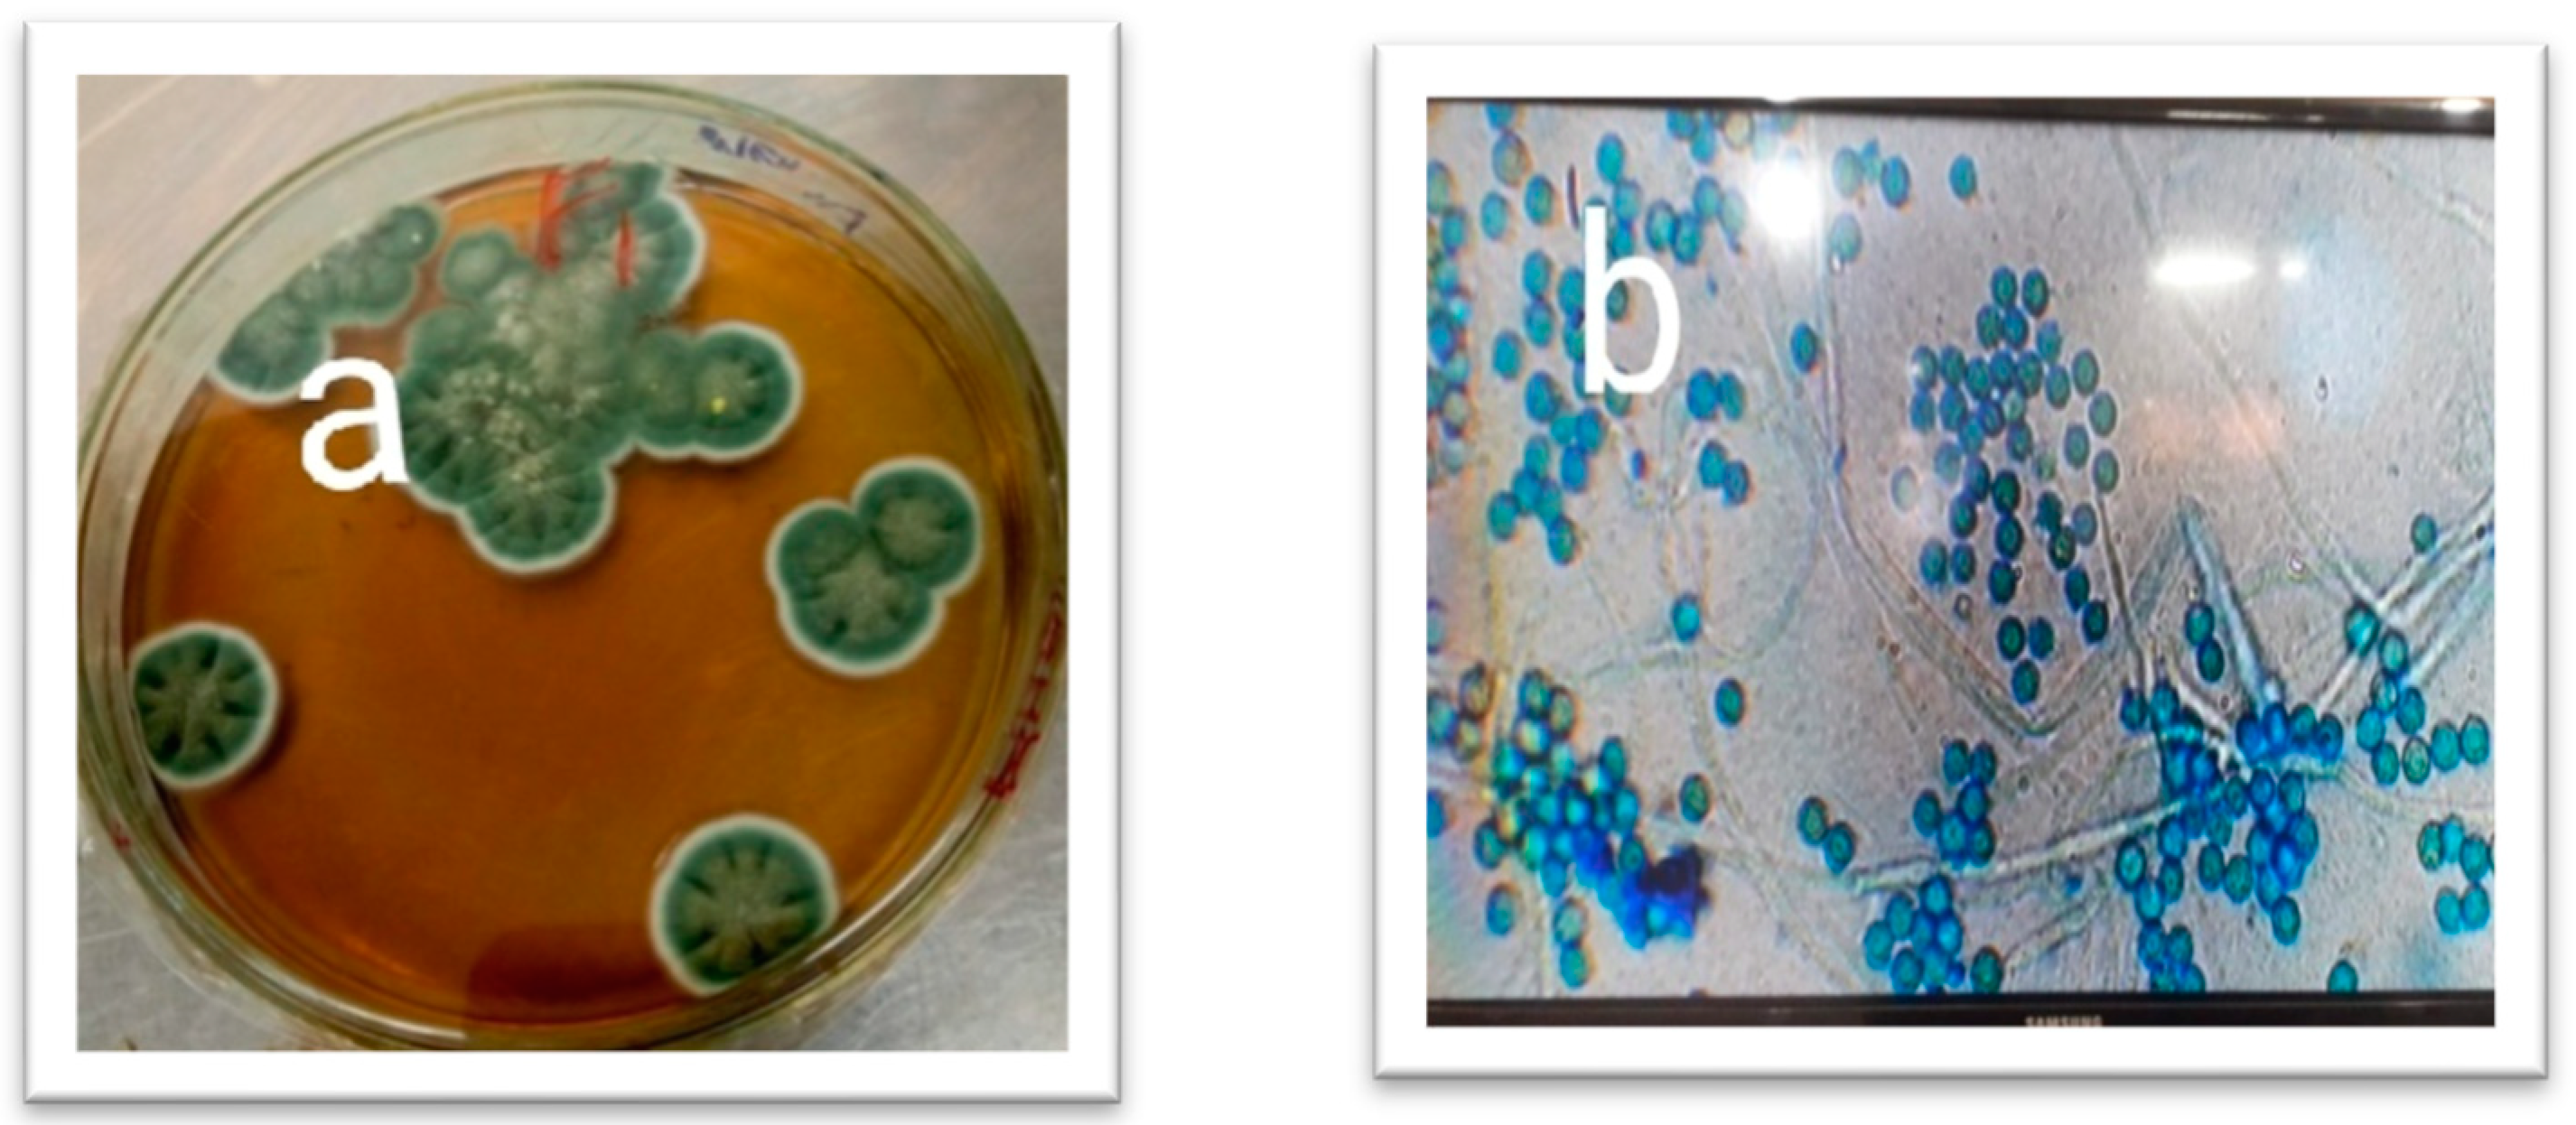

Biological Control of Hyalomma Ticks in Cattle by Fungal Isolates
Abstract
:Simple Summary
Abstract
1. Introduction
2. Materials and Methods
2.1. Soil Sample Collection
2.2. Tick Collection
2.3. Isolation of Fungi from the Soil Sample
2.4. Identification of the Isolated Fungi
2.5. Extraction of Spore-Free Filtrate from the Isolated Fungi
2.6. Preparation of Different Concentration
2.7. Adult Mortality Assay
2.8. Larval Mortality Assay
- P test: number of dead ticks
- P total: number of dead ticks + number of live ticks
3. Data Analysis
4. Results
4.1. Isolation and Identification of Fungi from the Soil Sample
4.2. Colony Morphology of the Fungal Isolates
5. In Vitro Bioassays
5.1. Adult Tick Mortality Assays against Fungal Isolates
5.2. Tick Larval Mortality Assay against Alternaria sp.
5.3. Tick Larval Mortality Assay against Fusarium sp.
5.4. Tick Larval Mortality Assay against Aspergillus sp.
5.5. Larval Mortality Assay against the Fungal Isolates
6. Discussion
7. Conclusions
Author Contributions
Funding
Institutional Review Board Statement
Informed Consent Statement
Data Availability Statement
Conflicts of Interest
References
- Sajid, M.S.; Iqbal, Z.; Shamim, A.; Siddique, R.M.; Jawad ul Hassan, M.; Rizwan, H.M. Distribution and abundance of ticks infesting livestock population along Karakorum from Mansehra to Gilgat, Pakistan. J. Hell. Vet. Med. Soc. 2017, 1, 81–88. [Google Scholar]
- Shahardar, R.A.; Niphadkar, S.M.; Narsapur, V.S.; Gante, M.L. Ixodid ticks of cattle and buffaloes in coastal districts (Konkan region) of Maharashtra state. Indian Vet. J. 1998, 75, 503–506. [Google Scholar]
- Gharbi, M.; Darghouth, M.A. A review of Hyalomma scupense (Acari, Ixodidae) in the Maghreb region: From biology to control. Parasite 2014, 21, 2. [Google Scholar] [CrossRef] [PubMed]
- Ghosh, S.; Ray, D.D.; Vanlahmuaka; Das, G.; Singh, N.K.; Sharma, J.K.; Azhahianambi, P. Progress in development of vaccine against Hyalomma anatolicum Indian scenario. Vaccine 2008, 26S, G40–G47. [Google Scholar] [CrossRef] [PubMed]
- Vial, L.; Stachurskia, F.; Leblond, A.; Huber, K.; Vourc’h, G.; René-Martellet, M.; Desjardins, I.; Balança, G.; Grosbois, V.; Pradier, S.; et al. Strong evidence for the presence of the tick Hyalomma marginatum Koch, 1844 in southern continental France. Ticks Tick-Borne Dis. 2016, 7, 1162–1167. [Google Scholar] [CrossRef] [PubMed]
- Doğan, M.; Devge, C.; Tanriöver Pata, Y.S.; Sönmezoğlu, M. Case report: Facial nerve paralysis due to intra-aural Hyalomma tick infestation. Türkiye Parazitoloji Derg. 2012, 36, 254–257. [Google Scholar] [CrossRef] [PubMed]
- Gharbi, M.; Sassi, L.; Dorchies, P.; Darghouth, M.A. Infection of calves with Theileria annulata in Tunisia: Economic analysis and evaluation of the potential benefit of vaccination. Veter-Parasitol. 2006, 137, 231–241. [Google Scholar] [CrossRef] [PubMed]
- Durrani, A.Z.; Shakoori, A.R.; Kamal, N. Bionomics of Hyalomma ticks in three districts of Punjab, Pakistan. J. Anim. Plant Sci. 2008, 18, 17–23. [Google Scholar]
- Uilenberg, G. Theilerial species of domestic livestock. In Advances in the Control of Theileriosis; Springer: Dordrecht, The Netherlands, 1981; pp. 4–37. [Google Scholar]
- Jongejan, F.; Uilenberg, G. The global importance of ticks. Parasitology 2004, 129, S3–S14. [Google Scholar] [CrossRef]
- Martins Joao, R.; Correa, B.L.; Ceresér, V.H.; Arteche C, C.P. A Situation Report on Resistance to Acaricides by the Cattle Tick Boophilus Microplus in the State of Rio Grande do Sul, Southern Brazil; Publicacion Especia. In Proceedings of the III Seminario Internacional de Parasitología Animal, Acapulco, Mexico, 11–13 October 1995. [Google Scholar]
- Asmaa, N.M.; ElBably, M.A.; Shokier, K.A. Studies on prevalence, risk indicators and control options for tick infestation in ruminants. Beni-Suef Univ. J. Basic App. Sci. 2014, 3, 68–73. [Google Scholar] [CrossRef]
- Pound, J.M.; Miller, J.A.; George, J.E.; Fish, D.; Carroll, J.F.; Schulze, T.L.; Daniels, T.J.; Falco, R.C.; Stafford, K.C.; Mather, T.N. The United States Department of Agriculture’s North-east area-wide tick control project: Summary and conclusions. Vector-Borne Zoonotic Dis. 2009, 9, 439–448. [Google Scholar] [CrossRef] [PubMed]
- Graf, J.F.; Gogolewski, R.; Leach-Bing, N.; Sabatini, G.A.; Molento, M.B.; Bordin, E.L.; Arantes, G.J. Tick control: An industry point of view. Parasitology 2004, 129, S427–S442. [Google Scholar] [CrossRef] [PubMed]
- Castro-Janer, E.; Rifran, L.; Gonzalez, P.; Piaggio, J.; Gil, A.; Schumaker, T.T. Rhipicephalus (Boophilus) microplus (Acari: Ixodidae) resistance to fipronil in Uruguay evaluated by in-vitro bioassays. Vet. Parasitol. 2010, 169, 172–177. [Google Scholar] [CrossRef] [PubMed]
- Honzakova, E. Relationship between numbers of eggs deposited and body weight of engorged Ixodes ricinus female. Folia Parasitol. 1975, 22, 37–42. [Google Scholar]
- Estrada-Peña, A.; Gonzalez, J.; Casasolas, A. The activity of Aspergillus ochraceus (Fungi) on replete females of Rhipicephalus sanguineus (Acari: Ixodidae) in natural and experimental conditions. Folia Parasitol. 1990, 37, 331–336. [Google Scholar]
- Hall, R.A.; Papierok, B. Fungi as biological control agents of arthropods of agricultural and medical importance. Parasitology 1982, 84, 205–240. [Google Scholar] [CrossRef]
- Barci, L.A.G. Biological control of the cattle tick Boophilus microplus (Acari, Ixodidae) in Brazil. Arq. Inst. Biol. 1997, 64, 95–101. [Google Scholar]
- Khattak, B.; Safi, A.U.R.; Sindhu, Z.U.D.; Attaullah, M.; Jamal, Q.; Khan, T.A.; Hussain, M.; Anjum, S.I.; Israr, M.; Khan, I.A. Biological control of Haemonchus contortus by fungal antagonists in small ruminants. Appl. Ecol. Environ. Res. 2018, 16, 5825–5835. [Google Scholar] [CrossRef]
- Gindin, G.; Samish, M.; Zangi, G.; Mishoutchenko, A.; Glazer, I. The susceptibility of different species and stages of ticks to entomopathogenic fungi. Exp. Appl. Acarol. 2002, 28, 283–288. [Google Scholar] [CrossRef]
- Sun, M.; Ren, Q.; Guan, G.; Li, Y.; Han, X.; Ma, C.; Yin, H.; Luo, J. Effectiveness of Beauveria bassiana sensu lato strains for biological control against Rhipicephalus (Boophilus) microplus (Acari: Ixodidae) in China. Parasitol. Int. 2013, 62, 412–415. [Google Scholar] [CrossRef]
- Granatstein, D.; MILES, C.A.; Snyder, W. Getting the Bugs to Work for You: Biological Control in Organic Agriculture Symposium Proceedings. 2004. Available online: https://rex.libraries.wsu.edu/esploro/outputs/conferencePaper/Getting-the-Bugs-to-Work-for/99900626292601842 (accessed on 3 October 2023).
- de Faria, M.R.; Wraight, S.P. Mycoinsecticides and mycoacaricides: A comprehensive list with worldwide coverage and international classification of formulation types. Biol. Control 2007, 43, 237–256. [Google Scholar] [CrossRef]
- Larone, D.H. Medically Important Fungi, a Guide to Identification; American Society for Microbiology: Washington, DC, USA, 1998. [Google Scholar]
- Syed Adnan, A.S. Isolation and Characterization of Secondary Metabolites from Marine Fungi of Arabian Sea and Mecrobial Transformation of Some Bioactive Compounds. Doctoral Dissertation, University of Karachi, Karachi, Pakistan, 2005. [Google Scholar]
- Leemon, D.M.; Jonsson, N.N. Laboratory studies on Australian isolates of Metarhizium anisopliae as a biopesticide for the cattle tick Boophilus microplus. J. Invertebr. Pathol. 2008, 97, 40–49. [Google Scholar] [CrossRef] [PubMed]
- Giles, J.R.; Peterson, A.T.; Busch, J.D.; Olafson, P.U.; Scoles, G.A.; Davey, R.B.; Pound, J.M.; Kammlah, D.M.; Lohmeyer, K.H.; Wagner, D.M. Invasive potential of cattle fever ticks in the southern United States. Parasites Vectors 2014, 7, 189. [Google Scholar] [CrossRef] [PubMed]
- Grisi, L.; Leite, R.C.; Martins, J.R.D.S.; Barros, A.T.M.D.; Andreotti, R.; Cançado, P.H.D.; Leon, A.A.P.D.; Pereira, J.B.; Villela, H.S. Reassessment of the potential economic impact of cattle parasites in Brazil. Rev. Bras. Parasitol. Vet. 2014, 23, 150–156. [Google Scholar] [CrossRef] [PubMed]
- Cafarchia, C.; Pellegrino, R.; Romano, V.; Friuli, M.; Demitri, C.; Pombi, M.; Benelli, G.; Otranto, D. Delivery and effectiveness of entomopathogenic fungi for mosquito and tick control: Current knowledge and research challenges. Acta Trop. 2022, 234, 106627. [Google Scholar] [CrossRef]
- García-García, J.C.; Montero, C.; Redondo, M.; Vargas, M.; Canales, M.; Boue, O.; Rodríguez, M.; Joglar, M.; Machado, H.; González, I.L.; et al. Control of ticks resistant to immunization with Bm86 in cattle vaccinated with the recombinant antigen Bm95 isolated from the cattle tick, Boophilus Microplus. Vaccine 2000, 18, 2275–2287. [Google Scholar] [CrossRef]
- Chen, P.H.; Chen, R.Y.; Chou, J.Y. Screening and evaluation of yeast antagonists for biological control of Botrytis cinerea on strawberry fruits. Mycobiology 2018, 46, 33–46. [Google Scholar] [CrossRef]
- Bordin, C.; Alves, D.S.; Alves, L.F.A.; de Oliveira, M.S.; Ascari, J.; Scharf, D.R. Fumigant activity of essential oils from Cinnamomum and Citrus spp. and pure compounds against Dermanyssus gallinae (De Geer) (Acari: Dermanyssidae) and toxicity toward the nontarget organism Beauveria bassiana (Vuill.). Vet. Parasitol. 2021, 290, 109341. [Google Scholar] [CrossRef]
- Kaaya, G.P.; Samish, M.; Hedimbi, M.; Gindin, G.; Glazer, I. Control of tick populations by spraying Metarhizium anisopliae conidia on cattle under field conditions. Exp. Appl. Acarol. 2011, 55, 273–281. [Google Scholar] [CrossRef]
- Barbieri, A.; Rico, I.B.; Silveira, C.; Feltrin, C.; Dall’agnol, B.; Schrank, A.; Lozina, L.; Klafke, G.M.; Reck, J. Field efficacy of Metarhizium anisopliae oil formulations against Rhipicephalus microplus ticks using a cattle spray race. Ticks Tick-Borne Dis. 2023, 14, 102147. [Google Scholar] [CrossRef]
- Frazzon, A.P.G.; Junior, I.d.S.V.; Masuda, A.; Schrank, A.; Vainstein, M.H. In vitro assessment of Metarhizium anisopliae isolates to control the cattle tick Boophilus microplus. Veter-Parasitol. 2000, 94, 117–125. [Google Scholar] [CrossRef] [PubMed]
- Fernandes, É.K.; Angelo, I.C.; Rangel, D.E.; Bahiense, T.C.; Moraes, Á.M.; Roberts, D.W.; Bittencourt, V.R. An intensive search for promising fungal biological control agents of ticks, particularly Rhipicephalus microplus. Vet. Parasitol. 2011, 182, 307–318. [Google Scholar] [CrossRef] [PubMed]
- Alonso-Díaz, M.A.; Fernández-Salas, A. Entomopathogenic Fungi for Tick Control in Cattle Livestock from Mexico. Front. Fungal Biol. 2021, 2, 657694. [Google Scholar] [CrossRef] [PubMed]
- Islam, W.; Adnan, M.; Shabbir, A.; Naveed, H.; Abubakar, Y.S.; Qasim, M.; Tayyab, M.; Noman, A.; Nisar, M.S.; Khan, K.A.; et al. Insect-fungal-interactions: A detailed review on entomopathogenic fungi pathogenicity to combat insect pests. Microb. Pathog. 2021, 159, 105122. [Google Scholar] [CrossRef]
- Fernandes, E.K.K.; Bittencourt, V.R.E.P.; Roberts, D.W. Perspectives on the potential of entomopathogenic fungi in biological control of ticks. Exp. Parasitol. 2012, 130, 300–305. [Google Scholar] [CrossRef]
- Kaaya, G.P.; Mwangi, E.N.; Ouna, E.A. Prospects for biological control of livestock ticks, Rhipicephalus appendiculatus and Amblyomma variegatum, using the entomogenous fungi Beauveria bassiana and Metarhizium anisopliae. J. Invert Pathol. 1996, 67, 15–20. [Google Scholar] [CrossRef]

| Fungal Isolates | Colony Morphology | ||
|---|---|---|---|
| Color | Shape | Elevation | |
| Alternaria sp. | Dark brown | Irregular | Septate |
| Aspergillus sp. | Greenish to black | Filamentous | Septate |
| Penicillium sp. | Gray | Circular | Septate |
| Fungal Culture Filtrate Concentrations (%) | Adult Tick Mortality (n = 5) | Mean Adult Tick Mortality | ||
|---|---|---|---|---|
| Fusarium sp. | Alternaria sp. | Aspergillus sp. | ||
| 100.0 (Positive control) | 5.0 | 5.0 | 4.6 | 4.60 |
| 75.0 | 3.3 | 4.3 | 3.0 | 3.53 |
| 50.0 | 2.3 | 3.0 | 2.3 | 2.53 |
| 25.5 | 1.0 | 1.6 | 1.3 | 1.30 |
| 12.5 | 0.3 | 0.6 | 0.4 | 0.43 |
| No Culture Filtrate (Negative Control) | 0 | 0 | 0 | 0 |
| Fungal Culture Filtrate Concentrations (%) | Tick Larval Mortality (n = 5) | Mean Larval Mortality | ||
|---|---|---|---|---|
| Fusarium sp. | Aspergillus sp. | Alternaria sp. | ||
| 100.0 (Positive control) | 5.0 | 5.0 | 4.0 | 4.67 |
| 75.0 | 3.6 | 3.0 | 3.0 | 3.20 |
| 50.0 | 2.3 | 2.0 | 1.6 | 1.97 |
| 25.5 | 1.3 | 1.0 | 1.0 | 1.10 |
| 12.5 | 0.6 | 0.3 | - | 0.30 |
| No CF (Negative control) | 0 | 0 | 0 | 0 |
Disclaimer/Publisher’s Note: The statements, opinions and data contained in all publications are solely those of the individual author(s) and contributor(s) and not of MDPI and/or the editor(s). MDPI and/or the editor(s) disclaim responsibility for any injury to people or property resulting from any ideas, methods, instructions or products referred to in the content. |
© 2023 by the authors. Licensee MDPI, Basel, Switzerland. This article is an open access article distributed under the terms and conditions of the Creative Commons Attribution (CC BY) license (https://creativecommons.org/licenses/by/4.0/).
Share and Cite
Wadaan, M.A.; Khattak, B.; Riaz, A.; Hussain, M.; Khan, M.J.; Fozia, F.; Iftikhar, A.; Ahmad, I.; Khan, M.F.; Baabbad, A.; et al. Biological Control of Hyalomma Ticks in Cattle by Fungal Isolates. Vet. Sci. 2023, 10, 684. https://doi.org/10.3390/vetsci10120684
Wadaan MA, Khattak B, Riaz A, Hussain M, Khan MJ, Fozia F, Iftikhar A, Ahmad I, Khan MF, Baabbad A, et al. Biological Control of Hyalomma Ticks in Cattle by Fungal Isolates. Veterinary Sciences. 2023; 10(12):684. https://doi.org/10.3390/vetsci10120684
Chicago/Turabian StyleWadaan, Mohammad Ahmad, Baharullah Khattak, Aneela Riaz, Mubbashir Hussain, Muhammad Jamil Khan, Fozia Fozia, Anisa Iftikhar, Ijaz Ahmad, Muhammad Farooq Khan, Almohannad Baabbad, and et al. 2023. "Biological Control of Hyalomma Ticks in Cattle by Fungal Isolates" Veterinary Sciences 10, no. 12: 684. https://doi.org/10.3390/vetsci10120684
APA StyleWadaan, M. A., Khattak, B., Riaz, A., Hussain, M., Khan, M. J., Fozia, F., Iftikhar, A., Ahmad, I., Khan, M. F., Baabbad, A., & Ziaullah. (2023). Biological Control of Hyalomma Ticks in Cattle by Fungal Isolates. Veterinary Sciences, 10(12), 684. https://doi.org/10.3390/vetsci10120684

